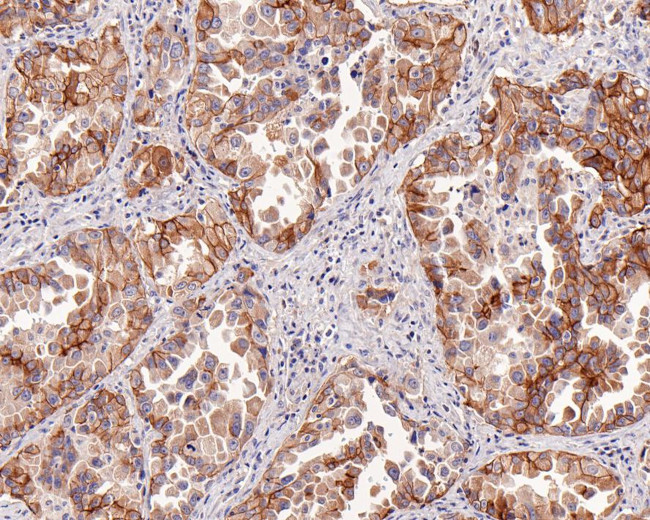
c-Met Antibody in Immunohistochemistry (Paraffin) (IHC (P))

Search
Invitrogen
c-Met Recombinant Mouse Monoclonal Antibody (A9A4-R)
{{$productOrderCtrl.translations['antibody.pdp.commerceCard.promotion.promotions']}}
{{$productOrderCtrl.translations['antibody.pdp.commerceCard.promotion.viewpromo']}}
{{$productOrderCtrl.translations['antibody.pdp.commerceCard.promotion.promocode']}}: {{promo.promoCode}} {{promo.promoTitle}} {{promo.promoDescription}}. {{$productOrderCtrl.translations['antibody.pdp.commerceCard.promotion.learnmore']}}
图: 1 / 2
c-Met Antibody (MA5-50654) in IHC (P)


Please note: We are reviewing Western blot images included in the antibody testing data in our catalog, including those provided by third parties. Unless expressly labeled or annotated as “raw-unedited”, Western blot images included in the antibody testing data in our catalog may have been edited, optimized or otherwise adjusted for presentation.
产品信息
MA5-50654
种属反应
宿主/亚型
Expression System
分类
类型
克隆号
抗原
偶联物
形式
浓度
规格
纯化类型
保存液
内含物
保存条件
运输条件
RRID
产品详细信息
Positive control: A549 cell lysate, HepG2 cell lysate, HT-29 cell lysate, Hela cell lysate, LO2 cell lysate, human lung adenocarcinoma tissue.
Predicted band size: 156 kDa
Subcellular Location: Membrane; Secreted.
靶标信息
MET (cMET) is a receptor-like tyrosine kinase whose dysregulation has been linked to many types of human malignancies. After activation of the ligand, MET interacts with the PI3-kinase subunit PIK3R1, PLCG1, SRC, GRB2, and STAT3. There interactions lead to the activation of signaling cascades including RAS-ERK, PI3, kinase-AKT, and PLCgamma-PKC. MET plays a role in embryonic development including gastrulation, development of muscles and neurons, angiogenesis, and kidney formation. It also plays a role in adults including wound healing, organ regeneration, and tissue remodeling. MET has been linked to cancers including gastric, renal, and breast; therefore, making it a target for cancer therapeutics and diagnostic testing.
仅用于科研。不用于诊断过程。未经明确授权不得转售。
篇参考文献 (0)
生物信息学
蛋白别名: cMet; EC 2.7.10.1; Hepatocyte growth factor receptor; HGF receptor; HGF-SF receptor; HGF/SF receptor; oncogene MET; Proto-oncogene c-Met; sc MET; Scatter factor receptor; SF receptor; soluble c met; Tyrosine-protein kinase Met
基因别名: MET
Entrez Gene ID: (Human) 4233